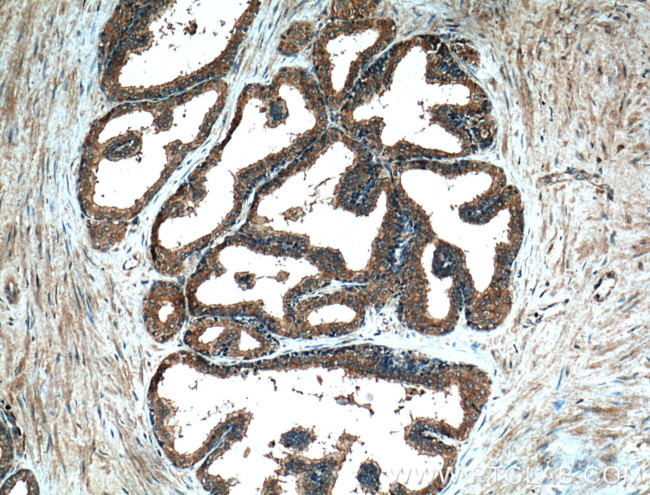
PLB1 Antibody in Immunohistochemistry (Paraffin) (IHC (P))

Search
Proteintech
PLB1 Polyclonal Antibody
{{$productOrderCtrl.translations['antibody.pdp.commerceCard.promotion.promotions']}}
{{$productOrderCtrl.translations['antibody.pdp.commerceCard.promotion.viewpromo']}}
{{$productOrderCtrl.translations['antibody.pdp.commerceCard.promotion.promocode']}}: {{promo.promoCode}} {{promo.promoTitle}} {{promo.promoDescription}}. {{$productOrderCtrl.translations['antibody.pdp.commerceCard.promotion.learnmore']}}
产品信息
26835-1-AP
种属反应
宿主/亚型
分类
类型
抗原
偶联物
形式
浓度
规格
纯化类型
保存液
内含物
保存条件
运输条件
产品详细信息
Immunogen sequence: QIHTSPRKS TLEGQLWPET LKNSPFPCNP NKLGVNMPSK SVHSLKPSDI KFVAAIGNLE IPPDPGTGDL EKQDWTERPQ QVCMGVMTVL SDIIRYFSPS VPMPVCHTGK RVIPHDGAED LWIQAQELVR NMKENLQLDF QFDWKLINVF FSNASQCYLC PSAQQNGLAA GGVDELMGVL DYLQQEVPRA FVNLVDLSEV AEVSRQYHGT WLSPAPEPCN CSEETTRLAK VVMQWSYQEA WNSLLASSRY SEQESFTVVF QPFFYETTPS LHSEDPRLQD STTLAWHLWN RMMEPAGEKD EPLSVKHGRP MKCPSQESPY LFSYRNSNYL TRLQKPQDKL EVREGAEIRC PD (22-372 aa encoded by BC150633)
靶标信息
This gene encodes a membrane-associated phospholipase that displays lysophospholipase and phospholipase A2 activities through removal of sn-1 and sn-2 fatty acids of glycerophospholipids. In addition, it displays lipase and retinyl ester hydrolase activities. The encoded protein is highly conserved and is composed of a large, glycosylated extracellular domain composed of four tandem homologous domains, followed by a hydrophobic segment that anchors the enzyme to the membrane and a short C-terminal cytoplasmic tail. This gene has been identified as a candidate rheumatoid arthritis risk gene.
仅用于科研。不用于诊断过程。未经明确授权不得转售。
篇参考文献 (0)
生物信息学
蛋白别名: Lysophospholipase; Phospholipase A2; Phospholipase B; Phospholipase B/lipase; Phospholipase B1, membrane-associated; PLB/LIP; Triacylglycerol lipase; unnamed protein product
基因别名: PLB; PLB/LIP; PLB1
UniProt ID: (Human) Q6P1J6
Entrez Gene ID: (Human) 151056